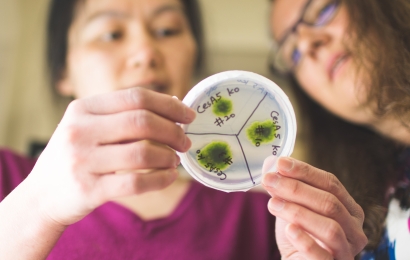
Scientists holding a slide of cells

For You: Faculty
Dartmouth educates and prepares students for a lifetime of learning and responsible leadership through a faculty dedicated to teaching and the creation of knowledge.
Protecting the research interests of students and faculty through the oversight of compliance with all relevant local, state and federal regulations.

In collaboration with faculty, the library provides learning experiences by engaging in all aspects of the educational continuum.
_0ed69.jpg?h=c6980913&itok=_IVt3uBb)
We efficiently deliver high-quality services and information, when and where they are needed, to enable the dynamic aspirations of Dartmouth’s faculty.
Whether you’re preparing for a press interview, addressing difficult public questions, establishing relationships with reporters and editors, or crafting and pitching an op-ed, our media relations team can help.
The Office of Human Resources at Dartmouth College provides assistance and resources to our faculty, staff, retirees, and prospective employees.
Some tools and resources offered to faculty to navigate life’s challenges.
Faculty News
View NewsResources by School
Manages educational policies, programs of instruction, and all matters relating to the effectiveness, development, and well-being of its faculty.
Teacher-scholars on the leading edge of theory and practice.
Dartmouth engineering faculty are both experts in their field and generalists in the classroom, able to teach a systems approach to engineering problem solving with wide-ranging applications.
The Geisel faculty dedicate themselves to the training of compassionate clinicians who possess outstanding clinical skills, a deep understanding of the scientific basis of health and disease, and proficiency in delivering care within complex social and economic environments.
Our faculty lead small, intense, research teams and our students enjoy unparalleled access to leaders in their fields—across all of our departments and professional schools.
Subscribe to Dartmouth News
Receive our most recent stories, photos, and videos in your email daily or once a week.